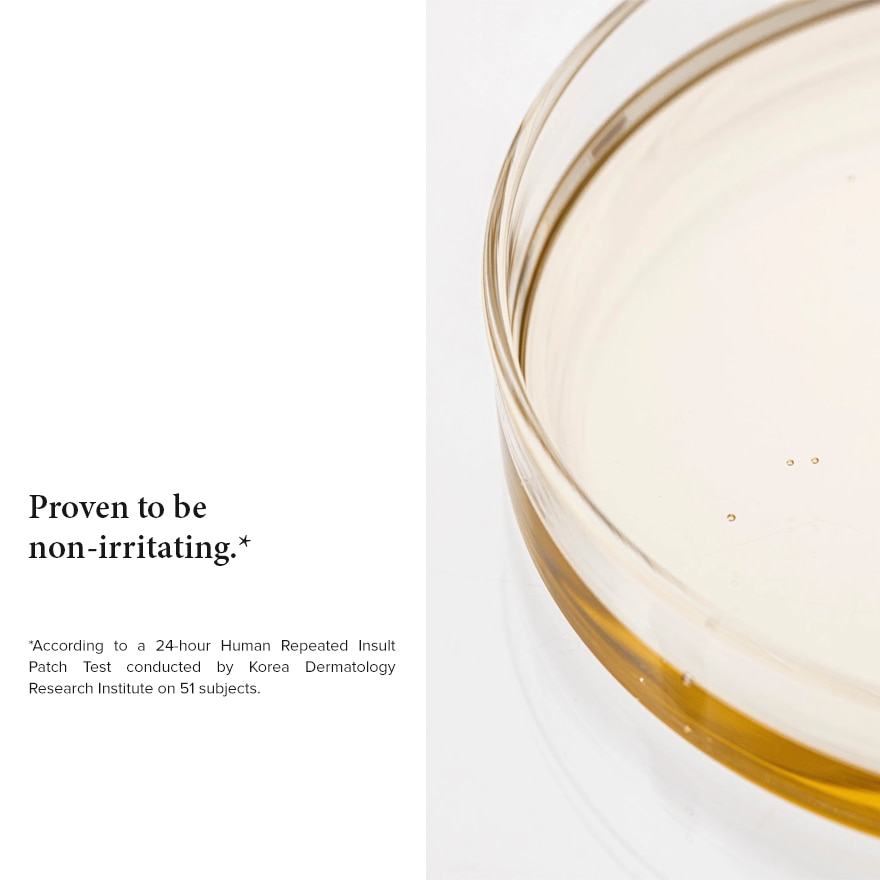
BEAUTY OF JOSEON Ginseng Cleansing Oil 210ml

Origin
South Korea
Product Usage
After pumping cleansing oil 1-2 times, gently massage onto a dry face. Then gently rinse with lukewarm water and cleanse with a foam cleanser once again.
Ingredients
Glycine soja (soybean) oil, cetyl ethylhexanoate, sorbeth-30 tetraoleate, olea europaea(olive) fruit oil, sorbitan sesquioleate, helianthus annuus (sunflower) seed oil,tocopherol, panax ginseng seed oil, ethylhexylglycerin, eclipta prostrata extract, panaxginseng root extract, melia azadirachta leaf extract, melia azadirachta flower extract,coccinia indica fruit extract, amber powder, moringa oleifera seed oil, solanummelongena (eggplant) fruit extract, curcuma longa (turmeric) root extract, ocimumsanctum leaf extract, corallina officinalis extract, bixa orellana seed oil, panax ginsengberry extract, panax ginseng root extract, butylene glycol, water, 1,2-hexanediol
Storage Information
Store in a cool dry place away from direct sunlight
Suitable For
Allergen Free Natural Paraben FreeWarnings
For external use only. Store at temperature not exceeding 25°C
Width
5.3
Height
5.3
Depth
19